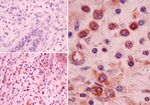
NALP2 Antibody in Immunohistochemistry (Paraffin) (IHC (P))

Search
Invitrogen
NALP2 Polyclonal Antibody
{{$productOrderCtrl.translations['antibody.pdp.commerceCard.promotion.promotions']}}
{{$productOrderCtrl.translations['antibody.pdp.commerceCard.promotion.viewpromo']}}
{{$productOrderCtrl.translations['antibody.pdp.commerceCard.promotion.promocode']}}: {{promo.promoCode}} {{promo.promoTitle}} {{promo.promoDescription}}. {{$productOrderCtrl.translations['antibody.pdp.commerceCard.promotion.learnmore']}}
产品信息
PA5-23315
宿主/亚型
分类
类型
抗原
偶联物
形式
浓度
规格
保存条件
运输条件
RRID
靶标信息
NALP2 belongs to a family of cytoplasmic proteins that have been implicated in cell responses to apoptotic and inflammatory stimuli. Unlike the prototypical NALP protein NALP1, NALP2 only contains a NACHT domain, leucine rich repeat (LRR), and pyrin-containing domain (PYD). This protein interacts with the adapter protein ASC in addition to CARD8 and caspase-1 to form an inflammasome with high proIL-1-b-processing activity and is thought to function as a modulator of NF-kappa-B and procaspase-1 activation in macrophages. It has also been suggested that NALP2, in addition to other NALP family members, can act as innate sensors of pathogens in a manner similar to the toll-like receptors (TLRs). At least two alternatively spliced transcript variants encoding distinct isoforms have been found for NALP2.
仅用于科研。不用于诊断过程。未经明确授权不得转售。